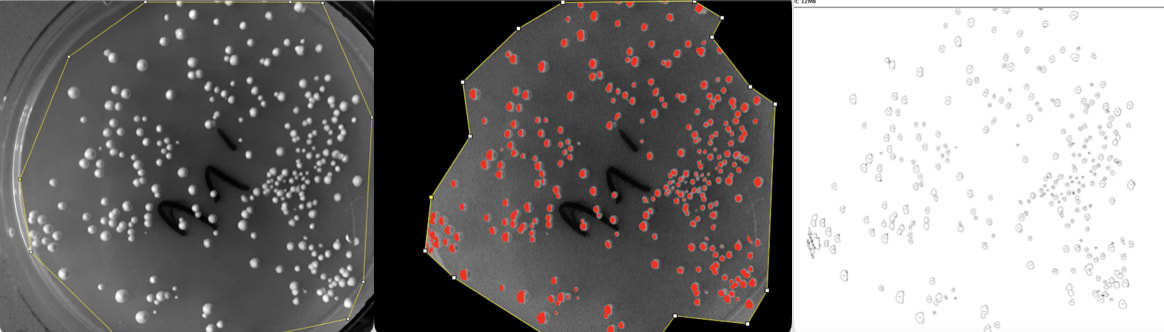

Thanks to David Jordan at Living Physics for the support. All mistakes are mine.
In my last post, I measured the effect of UV on yeast. But when I grew the solution on agar plates, they got contaminated.
So, I tried again. This time with sterile technique.
I made a 70% ethanol solution, and ran it through the pump to kill any contaminants before each run.
When the pump was in action and taking solution out of the tube, I lighted an ethanol lamp to create an updraft of air. This updraft prevents contaminants from getting in the tube, since its open. It’s cheaper than a Bunsen burner.
After running the yeast through UV, and before plating the solution, I first dipped a glass rod in pure ethanol. Then put it in the flame. I waved the rod in the air for a few seconds to cool it. Then I dipped it in the treated yeast solution and spread it on the plate.
After five days of growing, my yeast grew without contaminants. You can see a dramatic reduction from left to right as I increase the dose. Although, at the highest level of dose, the colony increases from the second highest. Weird.
To count the colonies automatically, I used Fiji. I increased the contrast, set a threshold to detect the high contrast colonies, then used Fiji’s particle analysis tool.
This gave me the following data. It fits the expected model of exponential decay, with a susceptibility parameter at k = 0.003.
That being said, the anomaly at the end really bugs me. I am trying to figure out what happened, so I’m going to repeat the experiment, but this time increase the sterile-ness with a laminar flow hood. I also will write a post to compare my measured coefficient with the literature.
.png)